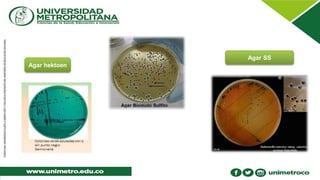
Agar hektoen
Agar SS

Salmonella es un bacilo gramnegativo que causa una variedad de enfermedades como la fiebre tifoidea y la salmonelosis no tifoide. La fiebre tifoidea se produce por S. typhi y S. paratyphi y causa fiebre, dolor abdominal y puede diseminarse sistémicamente. La salmonelosis no tifoide comúnmente causa gastroenteritis aguda por especies como S. enteritidis y S. typhimurium. El documento también describe la estructura, transmisión, patogénesis, manifestaciones clí